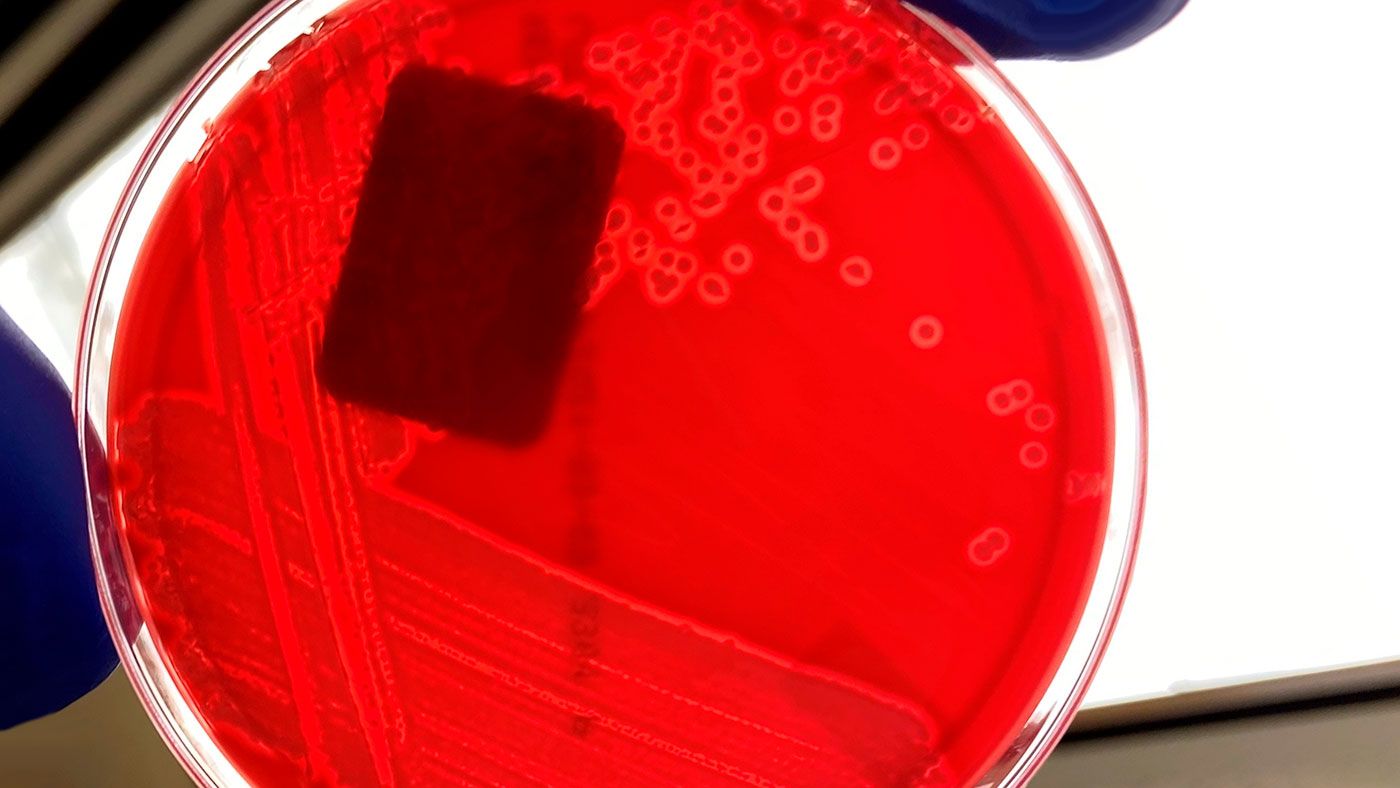
Abbildung 1: Reinkultur von h&auml;molytischen E. coli auf einer Blutagarplatte. Man beachte die hellen Bereiche um jede Bakterienkolonie, die auf eine H&auml;molyse hinweisen (Aufl&ouml;sung von Blut auf der Agarplatte). Bildnachweis: Iowa State University, Veterin&auml;rdiagnostisches Labor, Abteilung Bakteriologie

ELISA-Test als Diagnoseinstrument (2/2): Interpretation der Ergebnisse
Bei der Interpretation eines positiven oder negativen ELISA-Ergebnisses sind die folgenden Punkte zu beachten.
Aktuelles, Veranstaltungen und Nachrichten aus dem Schweinesektor
Liste mit allen Veranstaltungen, die in Verbindung zum Schweinesektor stehen. Sie können die Informationen sortieren, um nur bestimmte Bereiche zu sehen.
Zweiwöchentlicher Newsletter über alle Updates bei 3tres3.com/de
Schweinegesundheit: Neuigkeiten und Artikel zu PRRS, PCV2, Biosicherheit etc., Leitfaden Schweinekrankheiten, Pathologie-Atlas, klinische Fälle ...
Eine anschauliche und praxisnahe Schritt-für-Schritt-Anleitung zur Durchführung einer Nekropsie bei einem Schwein.
Dieser Simulator berechnet die benötigte Menge an Arzneimitteln, um bei Verwendung eines Dosierers über das Trinkwasser zu behandeln.
Meinungen und Einschätzungen von Schweine-Experten
Zweiwöchentlicher Newsletter über alle Updates bei 3tres3.com/de
Schweinepreise nach Ländern. Schweineproduktion und Handel. Aktuelles von den Schweine- und Rohstoffmärkten
Die aktuellen Schweinepreise und ihre Entwicklung. Hier finden Sie die Schweinepreise von über 20 Ländern in Europa, Amerika und Asien.
Abbildungen und Trends von Schweinezahlen,Produktionsdaten, Handel mit Schweinefleisch.
Globale Produktions- und Handelsdaten für die wichtigsten Rohstoffe
Zweiwöchentlicher Newsletter über alle Updates bei 3tres3.com/de
Artikel über Ernährung und Schweinefütterung, Eigenschaften der Roh- und Zusatzstoffe in Schweinefuttermitteln. Rohstoffpreise
Globale Produktions- und Handelsdaten für die wichtigsten Rohstoffe
Verwenden Sie dieses Tool, um Probleme mit der Futterverwertung zu diagnostizieren. Klicken Sie auf das Flussdiagramm oder auf die Schaltflächen im Text, um durch die verschiedenen Abschnitte des Tools zu navigieren.
Zweiwöchentlicher Newsletter über alle Updates bei 3tres3.com/de
Artikel über Genetik und Schweinereproduktion: genetische Verbesserung, Genomik, künstlichen Besamung, Einsatz von Hormonen
Vergleichen Sie Daten, berechnen Sie die Anzahl der Sauen-, Aufzucht- und Mastplätze und veranschaulichen Sie Ihre Aufgaben je nach Art des PMS.
Dieses Programm erlaubt Ihnen die Remontierungsrate für Ihren Bestand zu berechnen
Mit diesem Tool können Sie herausfinden, warum Ihre Abferkelrate nicht ideal ist. Klicken Sie auf das Flussdiagramm oder auf die Schaltflächen im Text, um durch die verschiedenen Abschnitte des Tools zu navigieren.
Zweiwöchentlicher Newsletter über alle Updates bei 3tres3.com/de
Management, Management in der Schweinehaltung, Arbeitsplanung in allen Produktionsphasen: Deckmanagement, Aufzucht und Mast, Gruppenabferkelung
Vergleichen Sie Daten, berechnen Sie die Anzahl der Sauen-, Aufzucht- und Mastplätze und veranschaulichen Sie Ihre Aufgaben je nach Art des PMS.
Dieses Programm erlaubt Ihnen die Remontierungsrate für Ihren Bestand zu berechnen
Zweiwöchentlicher Newsletter über alle Updates bei 3tres3.com/de
Einrichtung und Ausstattung von Schweinehaltungsbetrieben: bauliche Anlagen, Klimatechnik, Fütterungssysteme etc.
Zweiwöchentlicher Newsletter über alle Updates bei 3tres3.com/de
Die Qualität und die Unabhängigkeit unseres Inhalts ist es, was uns ausmacht. Erfahren Sie mehr über die Autoren, die das ermöglichen. Unser Ziel ist eine virtuelle Gemeinschaft mit fortschrittlichen Benutzern aus dem Schweinesektor.
Ausbildung:
Abschluss an der Iowa State University 1989 mit einem Bachelor of Science in Tierwissenschaft
Doktor der Tiermedizin (DVM) 1993 an der Iowa State University
Master in öffentlicher Gesundheit (MPH) 2004 an der Iowa State University
Zertifiziert durch das American College of Veterinary Preventive Medicine im Jahr 2006 (ACVPM-Diplom)
Bisherige berufliche Laufbahn:
2007 - heute: Assistenzprofessor für veterinärmedizinische Diagnostik und Nutztiermedizin. Seine Tätigkeit beinhaltet Lehre, Forschung, Berufspraxis und Veröffentlichungen. Er unterrichtet sowohl im Hauptstudiengang Tiermedizin als auch in Grund- und Aufbaustudiengängen. Sein Forschungsinteresse gilt der Übertragung von Infektionskrankheiten, darunter PRRS und Mycoplasma hyopneumoniae, Clostridium spp und MRSA, der Biosicherheit und den Infektionskrankheiten, die die öffentliche Gesundheit gefährden.
2004-2007 – Fachtierarzt an der Iowa State University. Zusammenarbeit mit dem Zentrum für Lebensmittelsicherheit und öffentliche Gesundheit sowie mit der Abteilung für veterinärmedizinische Diagnostik und Nutztiermedizin. Schwerpunkte: Lehrtätigkeit, Berufspraxis und Veröffentlichungen. Spezialisiert auf die Veterinärmedizin in der Schweineproduktion, die Übertragung von Infektionskrankheiten, Biosicherheit und Infektionskrankheiten, die die öffentliche Gesundheit gefährden.
1993-2004 – Tätigkeit in der Privatpraxis Valley Veterinary Center mit sechs auf verschiedene Tierarten spezialisierten Tierärzten in Cherokee, Iowa. Seine Tätigkeit umfasste die ambulante Behandlung von Großtieren sowie Managementdienstleistungen für Schweinezuchtbetriebe. Praxisklientel: 50 % Schweine, 30 % Rinder (Rindermast und Kühe), 15 % Kleintiere sowie 5 % Pferde & andere. In den letzten Jahren beschäftigte er sich hauptsächlich mit dem Schweineproduktionsmanagement der Kunden und der Verwaltung der Praxis. Er war für die Registerdatenbanken der Praxis (PigCHAMP® y CowCalf5®), die Personalverwaltung und die Buchführung verantwortlich. Zu seinen Managementdienstleistungen für die Kunden gehörten unter anderem routinemäßige Kontrollen der Bestände in seiner Eigenschaft als Personal- und Betriebsmanager mehrerer Betriebe.
Mitgliedschaft in Fachgremien:
American Veterinary Medical Association (AVMA)
American Association of Bovine Practitioners (AABP)
American Association of Swine Veterinarians (AASV)
Jurymitglied bei Seminarpräsentationen von Studenten (2006 – 2007)
Ko-Vorsitzender bei Seminarpräsentationen von Studenten (2007)
Vorsitzender bei Seminarpräsentationen von Studenten (2008 bis heute)
Mitglied des Ausschusses für Hochschulaktivitäten (2007 bis heute)
Mitglied des Ausschusses für ausländische Tierkrankheiten (2008 bis heute)
Iowa Veterinary Medical Association (IVMA)
American College of Veterinary Preventive Medicine (ACVPM)
Prüfungsausschuss des ACVPM (2007 – 2008)
Iowa Pork Producers Association (IPPA)
Ausschuss für Schweinegesundheit/Tierschutz (2007 bis heute)
National Pork Board (NPB)
Unterausschuss für Produktionssicherheit und öffentliche Gesundheit (2007 bis heute)
Grant Reviewer für Vorschläge im Bereich der Schweinegesundheit (2007 bis heute)
Grant Reviewer für Vorschläge im Bereich der öffentlichen Gesundheit (2008 bis heute)
Aktualisierter Lebenslauf 24-Okt-2012

Bei der Interpretation eines positiven oder negativen ELISA-Ergebnisses sind die folgenden Punkte zu beachten.

Wie gut kennen Sie sich mit ELISA-Tests aus? Hier erfahren Sie, wie der Test funktioniert, was er erkennt und wie die Ergebnisse zu interpretieren sind.

Wie ein negatives oder positives PCR-Ergebnis zu interpretieren ist, mit konkreten Beispielen, was passieren könnte.

Wie die PCR funktioniert und was bei der Interpretation der Ergebnisse zu beachten ist.

Welche labordiagnostischen Verfahren kann man zur Diagnose von Streptococcus suis einsetzen? Welches Verfahren sollte man je nach Situation wählen? Wie sind die Ergebnisse zu interpretieren?

Welche labordiagnostischen Verfahren kann ich zur Diagnose von Ileitis benutzen? Welches Verfahren sollte man je nach Situation wählen? Wie sind die Ergebnisse zu interpretieren?
Welche labordiagnostischen Methoden kann ich zur Diagnose der Ödemkrankheit einsetzen? Welches Verfahren sollte je nach Situation gewählt werden? Wie sind die Ergebnisse zu interpretieren?

Welche labordiagnostischen Verfahren kann man zur Diagnose von E. coli einsetzen? Welches Verfahren sollte je nach Situation gewählt werden? Wie sind die Ergebnisse zu interpretieren?

Welche labordiagnostischen Verfahren kann man zur Diagnose von PRRS benutzen? Welche Methode sollte je nach Situation gewählt werden? Wie interpretiert man die Ergebnisse?

Heute sind in Nordamerika fast alle Lieferanten von Zuchttieren zur Remontierung der Bestände frei von M.hyo.
Willkommen bei 333
Vernetzen Sie sich, tauschen Sie sich aus und interagieren Sie mit der größten Fachgemeinschaft des Schweinesektors.
Wir feiern 205489Nutzer bei 333!
AnmeldenSind Sie schon Mitglied?


